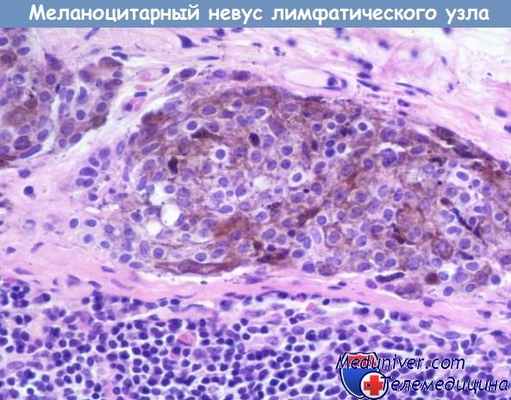
Невус лимфатического узла

Невус меланоцитарный лимфатических узлов
Добавил пользователь Alex Обновлено: 23.11.2025
Дагестанская государственная медицинская академия, Махачкала
Дагестанская государственная медицинская академия, Махачкала
Дагестанская государственная медицинская академия, Махачкала
Случай врожденного гигантского меланоцитарного волосяного невуса
Журнал: Клиническая дерматология и венерология. 2012;10(5): 42‑45
Эфендиева Г.А., Алиева П.М., Джумалиева М.Д. Случай врожденного гигантского меланоцитарного волосяного невуса. Клиническая дерматология и венерология. 2012;10(5):42‑45.
Éfendieva GA, Alieva PM, Dzhumalieva MD. A case of congenital giant melanocytic hairy nevus. Klinicheskaya Dermatologiya i Venerologiya. 2012;10(5):42‑45. (In Russ.).
Дагестанская государственная медицинская академия, Махачкала
Представлен случай редко встречающегося врожденного гигантского меланоцитарного волосяного невуса. Данное клиническое наблюдение демонстрирует необходимость оценки степени вероятности паранеопластического характера дерматоза.
Дагестанская государственная медицинская академия, Махачкала
Дагестанская государственная медицинская академия, Махачкала
Дагестанская государственная медицинская академия, Махачкала
В последние десятилетия в связи с активной инсоляцией, разного рода иммунными и эндокринными расстройствами в практике врачей-дерматовенерологов стали чаще встречаться различные новообразования кожи (меланоцитарные невусы, базально-клеточный рак кожи, папилломы, меланома и другие опухоли). Актуальность проблемы обусловливается возможной злокачественной трансформацией некоторых новообразований.
В последние годы важную роль отводят изучению патогенетических механизмов развития новообразований кожи, принципов лечения с применением современных методов лечения. В соответствии с классификацией J. Bhawan [1] выделяют 4 основные группы меланоцитарных невусов: эпидермального меланоцитарного происхождения, смешанного дермального и эпидермального происхождения, предшественников меланомы (врожденный и диспластический). Пигментные невусы образуются в результате скопления в разных отделах кожи невоидных клеток, которые отличаются от нормальных меланоцитов отсутствием отростков, редко содержат меланин и не передают его кератиноцитам. Невусы делятся на врожденные и приобретенные.
В зависимости от локализации невоидных клеток различают пограничный невоклеточный (невусные клетки располагаются в нижнем слое эпидермиса), внутридермальный невоклеточный (невусные клетки обнаруживаются в средних и нижних частях дермы), а также сложный невус (сочетает гистологические признаки пограничного и внутридермального невусов). Механизмы озлокачествления не выяснены. Большинство ученых считают наиболее меланомоопасными невусами пограничный, голубой, смешанные невусы-предшественники меланомы, (невус Ота, гигантский пигментный невус), а также ограниченный предраковый меланоз Дюбрея [1].
Локализация гигантских невусов может быть разной (купальник, воротник, жилетка и др.), отдельные очаги могут располагаться строго с одной стороны, достигая срединной линии. Считается, что верхняя часть большинства невусов находится на средней линии спины. В области верхнего плечевого пояса обычно встречаются подобные пигментные невусы с обильным волосяным покровом, расположенные на коже плеч или верхних конечностей. Невусы нижних областей туловища, как правило, переходят на кожу нижних конечностей. При поражении лептоменингеальных оболочек возникает церебральный меланоз, сопровождающийся невусами огромных размеров или множественными невусами волосистой части головы и шеи. В литературе описано 30 случаев злокачественной меланомы, появившейся в гигантском невусе. Из них в 8 случаях меланома была выявлена сразу после рождения, в 12 — после 20 лет. Из 13 вскрытий в 9 обнаружены метастазы. Согласно мнению ряда авторов [2], очаг с локализацией по типу купальника является пренеопластическим гамартомным новообразованием.
Гигантский меланоцитарный невус может сочетаться с другими врожденными пороками развития — гидроцефалией, эпилепсией и др.
Меланоцитарные невусы являются потенциальными предшественниками меланомы. Их развитие связано, возможно, как с наследственными, так и с ненаследственными факторами. Вне зависимости от пола они возникают почти у 1% новорожденных и могут быть представлены пятнистыми, папулезными и узловыми элементами, формируются в период от 40 дней и до 6 мес внутриутробной жизни.
В зависимости от диаметра врожденные меланоцитарные невусы делят на маленькие (менее 1,5 см), средние (1,5—20 см) и гигантские (более 20 см в диаметре). Излюбленная локализация — нижняя часть туловища, верхняя часть спины, предплечья, грудь, проксимальные отделы верхних и нижних конечностей. У новорожденных невусы чаще бывают мелкие и средние, в юношеском возрасте могут быть средними и гигантскими. По мере роста ребенка участки склонны к потемнению и утолщению, рост волос отмечается в 95% случаев. Гигантские невусы трансформируются в меланому в 6—10% случаев.
В отличие от приобретенных меланоцитарных невусов, гистологически врожденные характеризуются повышенным количеством меланоцитов в базальном слое эпидермиса, отсутствием их в сосочковом слое дермы. Невусные клетки расположены вокруг придатков кожи, при гигантских врожденных невусах может происходить рост округлых и вытянутых невусных клеток вглубь, вплоть до подкожной жировой клетчатки. Злокачественное перерождение, как правило, начинается в дермо-эпидермальной зоне, реже — в более глубоких участках невуса.
Дифференциальную диагностику проводят с себорейным кератозом, ихтиозом, базалиомой, меланомой, а также с другими врожденными пигментными поражениями кожи, такими как монгольские пятна, пятна типа «кофе с молоком», лентиго, невус сальных желез, врожденный невус Беккара. При наличии очень темного цвета и неравномерной окраски можно думать о возможности диспластического меланоцитарного невуса или меланомы. Об этом свидетельствуют и изъязвления на поверхности. Врожденные меланоцитарные невусы растут в соответствии с ростом данного участка кожи, особенно в пубертатный период.
При рождении невусы возвышаются над уровнем кожи, со временем они могут приподниматься сильнее. Нередко вокруг невуса появляется ободок депигментации или наступает спонтанная ремиссия.
Редкий случай описан у годовалой девочки при сочетании невуса с диффузной астроцитомой, увеличившейся в диаметре на 3 см в течение 1 года. Такое описание дано в литературе впервые [3]. Также описаны случаи сочетанной патологии, например, с редким заболеванием, таким как туберозный склероз. Девушка 16 лет была госпитализирована с патологическим процессом, локализованным на границе с волосистой частью головы и распространенным до уровня чуть выше левой брови, что вызывало механический птоз. Пациентка родилась с пятном треугольной формы, покрывающим обширный участок волосистой части головы. Размер очага увеличивался в течение 8 лет. На рентгенограмме черепа и при ультразвуковом исследовании головного мозга выявлен отек мягких тканей височно-теменной области. Результаты магнитно-резонансной томографии головного мозга подтвердили наличие патологического очага размером 8,99×2,26 см. Гигантский невус был подтвержден результатами гистологического исследования [4].
Приведено описание гигантского невуса на туловище с крестцово-копчиковой неоплазмой у 2-летней девочки, которой проведено хирургическое вмешательство. Данные гистологии подтвердили доброкачественный характер процесса. При небольших образованиях целесообразна выжидательная тактика и здесь не требуется немедленное оперативное вмешательство [5]. Возможно сочетание меланоцитарного невуса с поражением гениталий [6]. В литературе описан единичный случай комбинации гигантского невуса (область шеи и головы) с плексиформной невриномой и злокачественной опухолью периферической нервной системы. По мнению авторов [7], не исключено взаимное происхождение всех трех указанных заболеваний. Имеется информация о распространении патологического процесса у 6-летнего мальчика вглубь до фасций и мышечной ткани в сакральной области [8].
По данным разных авторов [9], врожденный невус присутствует у 2–3% новорожденных. Риск развития меланомы пропорционален размеру, особенно если речь идет о поражении более 5% поверхности тела или более 20 см у подростков. Риск озлокачествления варьирует от 5 до 40%. Приводится описание невуса у 6-летней девочки (локализациея в области верхнего века), подвергшейся хирургической операции.
По данным индийских ученых, гигантскими волосяными невусами считаются очаги более 10 см, вероятность малигнизации составляет 4—6%. Есть информация о сочетании невусов с витилиго, диффузным липоматозом, болезнью Реклингхаузена [10].
На протяжении 10 лет в детском ожоговом центре проводились наблюдения за пациентами с целью клинической характеристики и оценки результатов лечения. Из них 64 и 36% составляли девочки и мальчики соответственно, представители европейской расы — 47%, латино — 19%. Возраст большинства пациентов соответствовал 1—10 годам (средний возраст 7 лет). В 89% случаев был представлен только 1 очаг поражения, наиболее распространенная локализация — лицо (64% случаев) и голова (17%). Результаты патогистологических исследований подтвердили доброкачественную природу патологического процесса у больных [11].
Лечение невусов зависит от степени риска перехода в меланому. При гигантских формах производят обширное иссечение с последующей пластикой. Обычно проводят детям в возрасте от 6 мес до 1 года. Если операция проводится в более поздние сроки, необходима биопсия пораженных участков.
Невусы маленьких и средних размеров иссекают до наступления пубертатного периода. Рекомендовано (по данным A. Rhodes) фотографическое наблюдение за больным. Атипично выглядящие врожденные меланоцитарные невусы с целью профилактики меланомы следует удалять немедленно, а доброкачественно выглядящие не рекомендуется удалять в младенческом и раннем детском возрасте, поскольку применение общей анестезии у детей до 10 лет связано с риском развития осложнений. Удаление в экстренном порядке показано при быстром росте невуса. За доброкачественными невусами следует наблюдать до достижения ребенком 10—12 лет.
На основании всего изложенного нам представляется интересным следующий клинический случай.
Больная Р., 35 лет, находилась на стационарном лечении и обследовании в женском кожном отделении Республиканского кожно-венерологического диспансера с диагнозом «гигантский меланоцитарный невус». Субъективные жалобы на умеренную болезненность в области высыпаний, легкий зуд. По данным анамнеза росла и развивалась соответственно возрасту, наличие туберкулеза и венерических болезней отрицает, другие соматические заболевания, наличие аллергических реакций не отмечает. Больна данным заболеванием с рождения. Беременность и роды у матери протекали без патологии. Размеры высыпаний увеличивались по мере роста ребенка. По месту жительства к врачам не обращалась. Обследование проходила в Москве. В связи с появившимися жалобами, нарастанием выраженности клинических проявлений направлена на госпитализацию в ГУ РКВД.
При осмотре общее состояние удовлетворительное. Больная нормостенического телосложения.
В легких везикулярное дыхание, хрипов нет. Тоны сердца ясные, ритмичные. Артериальное давление — 120/80 мм рт.ст., пульс — 76 ударов в минуту. Живот мягкий, безболезненный при пальпации. Печень у края реберной дуги. Симптом Пастернацкого отрицательный с обеих сторон. Физиологические отправления в норме. Периферические лимфатические узлы не пальпируются. Патологический процесс занимает обширные участки на коже туловища, конечностей, представлен высыпаниями темно-коричневого цвета с бугристой, бородавчатой поверхностью, участками выраженного гипертрихоза, местами определяются трещины кожи. При осмотре выявляются невусы средних размеров, диаметром 1,5 см, в виде разбросанных папул на коже живота (рис. 1—4). Рисунок 1. Высыпания гигантского невуса на коже живота. Рисунок 2. Высыпания гигантского невуса на коже туловища и правого бедра. Рисунок 3. Высыпания гигантского невуса на коже спины. Рисунок 4. Очаги меланоцитарного невуса на коже боковой поверхности туловища и передней поверхности правого бедра. Слившиеся крупные очаги занимают всю поясничную область, боковую правую поверхность туловища и переходят на область правого бедра, где гипертрихоз выражен в большой степени (рис. 5—6). Рисунок 5. Очаги меланоцитарного невуса на коже поясничной области и задней поверхности правого бедра. Рисунок 6. Высыпания гигантского волосяного невуса на коже спины и правого бедра.
При обследовании материала, взятого из очага поражения (цитологическое исследование), специфических изменений не выявлено. Рутинные клинико-лабораторные методы обследования без патологии. В стационаре больной выставлен клинический диагноз «врожденный гигантский волосяной меланоцитарный невус».
При повторной консультации признаков малигнизации и негативной динамики кожного процесса не наблюдалось. Во время курса лечения в стационаре ГУ РКВД наблюдалось уменьшение субъективной симптоматики в виде улучшения самочувствия, стихания болей в области высыпаний, уменьшения зуда.
Больная была взята под активное динамичное наблюдение в поликлиническое отделение РКВД.
Невус меланоцитарный лимфатических узлов
Невус меланоцитарный лимфатических узлов
Синоним: невусы узловые.
Определение. Доброкачественное меланоцитарное новообразование лимфатического узла, состоящее из невомеланоцитов.
Историческая справка. Первые публикации о наличии доброкачественных невусных клеток в лимфатических узлах появились в 60-х годах XX столетия.
Частота. Невомеланоциты в лимфатических узлах обнаруживают, как правило, при лимфаденэктомии по поводу меланомы кожи, рака молочной железы или по другим причинам. При лимфаденэктомии, не связанной с меланомой кожи, невомеланоциты в лимфатических узлах выявляются с частотой 0,3—7,3%. Если лимфаденэктомия связана с меланомой, то невомеланоциты при этом обнаруживаются в 22% случаев.
Этиология и патогенез меланоцитарного невуса лимфатических узлов. Невомеланоциты в лимфатических узлах происходят чаще из обычных приобретенных и врожденных невусов, а также из простых и клеточных голубых невусов и из невуса Шпиц. При этом вовлекаются те лимфатические узлы, которые дренируют область кожи с данными конкретными меланоцитарными образованиями. Существуют две теории, которые объясняют появление невомеланоцитов в лимфатических узлах.
Во-первых, в период развития невомеланоциты оказываются окруженными развивающейся тканью узла, которая депонирует данные меланоцитарные клетки. Это положение подтверждается тем, что обнаруживается связь невомеланоцитов лимфатических узлов с врожденными невусами.
Во-вторых, может существовать пассивный переносчик из кожного образования в лимфатический узел. Такие вещества, как уголь, чернила для татуировок, радиоактивные коллоиды, без труда проникают в дренирующий лимфатический узел. Видимо, невомеланоциты могут распространяться тем же путем.
Невомеланоциты преимущественно выявляются в составе капсулы лимфатического узла, реже — в его паренхиме.
Существует два возможных механизма появления невусных клеток в паренхиме лимфатического узла.
Во-первых, невомеланоциты могут переместиться в паренхиму вследствие инцизионной биопсии.
Во-вторых, невомеланоциты в паренхиме являются фактически метастатическими клетками из злокачественного голубого невуса или из предшественника меланомы (атипичной формы голубого клеточного невуса).
Гистология меланоцитарного невуса лимфатических узлов. Невомеланоциты лимфатических узлов имеют сходство с клетками в образовании на коже.
Иммуногистохимия. Применение стандартных иммуногистохимических анализов может помочь выявить локализацию и клеточные свойства невомеланоцитов в срезах лимфатического узла. Отсутствие маркеров пролиферации (Ki67) и, возможно, высокие уровни иммуногистохимических маркеров р16 свидетельствуют в пользу доброкачественного образования.
Полимеразная цепная реакция не позволяет дифференцировать доброкачественный и злокачественный характер меланоцитарного поражения лимфатического узла.
Дифференциальный диагноз меланоцитарного невуса лимфатических узлов. Невомеланоциты в лимфатических узлах имитируют метастазы меланомы, что требует тщательной дифференциальной диагностики этих процессов.
Течение и прогноз. Пациенты, имеющие невомеланоциты в лимфатических узлах, никаких жалоб не предъявляют.
Лечение меланоцитарного невуса лимфатических узлов. В связи с подозрением на меланому пациентов необходимо обследовать для исключения метастазов. При доброкачественных узловых невусах лечения не требуется. После хирургического вмешательства можно наблюдать такие осложнения, как формирование рубца или лимфедему. Ошибочное принятие доброкачественных узловых скоплений за злокачественные может привести к ненужному иссечению регионального лимфатического узла и лечению системными препаратами.
И напротив, принятие злокачественных узловых клеток за доброкачественные не насторожит пациента в отношении плохого прогноза и тем самым время для лечения будет упущено.
Редактор: Искандер Милевски. Дата обновления публикации: 18.3.2021
Невус

Невус (родинка, родимое пятно) – это доброкачественное опухолевидное новообразование, состоящее из меланоцитов (пигментных клеток). Он имеет яркую окраску – коричневую, черную, красную или фиолетовую и может быть плоским или возвышаться над кожей. Невусы бывают врожденными и приобретенными. И те, и другие наблюдаются у более чем 90% людей. В среднем у человека около 20 невусов на теле, однако это количество может колебаться от 3 до 100.Болезнь невус или нет? Сами по себе родинки не опасны и не причиняют никакого вреда здоровью. Их следует удалять лишь в том случае, если они доставляют эстетические или физические неудобства или расположены в местах, где их легко повредить механическим воздействием (например, трением об одежду). Однако невусы способны перерождаться в меланому (рак кожи) – злокачественное новообразование. Поэтому при наличии «подозрительных» родинок рекомендуется регулярно наблюдаться у дерматолога, а при признаках их перерождения в меланому незамедлительно обращаться к врачу.
Виды невусов и причины появления
Невус – узелок с обычно гладкой поверхностью. Некоторые родинки имеют ороговевшую или бородавчатую поверхность. Внутри таких образований могут расти волоски.

Невусы образуются из пигментных клеток, находящихся между двумя слоями кожи: эпидермисом и дермой. Меланоциты вырабатывают пигмент (меланин) под воздействием ультрафиолетовых лучей. Этим объясняется возникновение загара после длительного нахождения на солнце. Невусы появляются при размножении меланоцитов в слоях кожи.
Родинки могут быть:
- Врожденными – закладываются еще во внутриутробный период.
- Приобретенными – возникают под воздействием провоцирующих факторов.
Причины появления родинок во внутриутробный период:
- Наследственную предрасположенность «склонность» к образованию родинок способна передаваться генетически.
- Нарушения нормального течения беременности – токсикоз, угрозу прерывания.
- Аллергические реакции матери.
- Токсическое воздействие.
- Наличие у беременной патологий мочевыделительной системы.
- Лучевое облучение матери.
- Злоупотребление женщиной спиртными напитками (не только во время, но и до беременности).
- Прием гормональных препаратов до зачатия.
К провоцирующим факторам, повышающим вероятность появления приобретенных родинок, относятся:
- Ультрафиолетовое излучение.
- Гормональные нарушения.
- Травмы участка кожи.
- Вирусные и бактериальные инфекции.
- Воздействие радиации или рентгеновских лучей.
Справка! Так как возникновению невусов способствует изменение гормонального фона, новые родинки часто появляются в период полового созревания, во время беременности и менопаузы.
Существует теория, согласно которой все невусы являются врожденными, однако при появлении ребенка на свет они невидимы и проявляются позднее, в течение жизни. Действительно, всего 4-10% детей рождаются с невусами. В 90% случаев это мелкие родинки (менее 4 мм). 8% невусов у новорожденных – средних размеров, а с гигантскими появляются на свет всего 2% детей. Активно появляться они начинают после 5 лет жизни. К 15-16 годам у большинства подростков есть невусы. С возрастом количество родинок уменьшается. После 80 лет примерно у половины людей невусы на теле исчезают совсем.
Родинки классифицируются по размеру (диаметру):
- Мелкие – до 1,5 мм.
- Средние – до 10 мм.
- Крупные – более 10 мм.
- Гигантские – полностью охватывают какую-то часть тела.
Склонность к перерождению в меланому имеют, как правило, средние и крупные родинки.
Также врожденные невусы подразделяются на виды в зависимости от расположения:
- Эпидермальные – меланоциты скапливаются в верхнем слое кожи, эпидермисе.
- Внутридермальные – находятся в глубоких слоях кожи.
- Пограничные – расположены между эпидермисом и дермой.
В меланому способны перерождаться не все невусы кожи. Поэтому их делят на:
К меланомоопасным относят:
- Пограничный пигментный невус – плоский узелок с гладкой сухой поверхностью, без наличия в нем волосков. Чаще всего достигает 1 см в диаметре, однако его диаметр может колебаться от нескольких миллиметров до нескольких сантиметров. Пограничные невусы имеют разную окраску – от светло-коричневого до черного.
- Невус Ота – одно крупное пигментное пятно (или множественные, сливающиеся воедино) сине-черного цвета, обычно располагается на лице.
- Гигантский пигментный невус – относится к врожденным, растет вместе с ребенком и способен достигать в диаметре 10-40 см, имеет серую или черную окраску и неровную поверхность (может быть покрыт трещинами), в нем часто наблюдаются волоски.
- Невус Дюбрея – плоский, 2-6 см в диаметре, имеет неровные края и неравномерную серо-коричнево-синюю окраску и визуально напоминает географическую карту, поверхность может быть покрыта узелками и бляшками.
- Синий невус – новообразование с четкими границами, имеющее вид полусферы. Его диаметр редко превышает 1 см. Имеет голубую или синюю, иногда коричневую окраску. Поверхность мягкая, лишена волос.
- Диспластический невус – имеет размытые неровные границы, неравномерную окраску (смесь светло- и темно-коричневых оттенков), поверхность покрыта пятнами или узелками, в диаметре обычно превышает 6 мм.
Справка! Прилагательное «меланомоопасный» не означает, что доброкачественное образование обязательно станет злокачественным. Это говорит лишь о том, что у вышеперечисленных родинок есть такая способность. Если у вас есть меланомоопасный невус на лице или теле, за ним необходимо пристально наблюдать и обращаться к врачу при малейших подозрениях на начало перерождения.
Меланомонеопасными являются такие невусы, как:
- Внутридермальный меланоцитарный – наиболее распространенный вид родинки, представляет собой небольшое мягкое округлое коричневое образование, способен возникнуть на любом участке тела.
- Папилломатозный – напоминает папиллому, имеет несимметричную форму, чуть возвышается над поверхностью кожного покрова, может менять размеры в течение жизни (увеличиваться или уменьшаться), располагается на теле, лице или волосистой части головы.
- Фиброэпителиальный – мягкое новообразование на ножке, достигает до 15 мм в диаметре, имеет телесную, коричневую, черную, розовую или фиолетовую окраску, внутри родинки растут волоски.
- Монгольское пятно – врожденное плоское образование, имеющее синеватую окраску, в диаметре может достигать нескольких сантиметров (иногда десятков сантиметров), чаще всего располагается на ягодицах или в области крестца, обычно проходит само собой к 5-13 годам.
Признаки перерождения невуса в меланому
Симптомами озлокачествления невуса являются:
- Изменение цвета (снижение или повышение пигментации).
- Уплотнение родинки.
- Разрастание новообразования – в диаметре или в высоту.
- Покраснение.
- Наличие на родинке язв.
- Кровотечения из невуса.
- Возникновение вокруг родинки или родимого пятна черных точек.
- Выпадение из невуса волос.
- Ощущение тепла, зуда или жжения в области новообразования.
- Увеличение регионарных лимфатических узлов.
При наличии таких признаков следует незамедлительно обратиться к дерматологу и онкологу.
Причины перерождения невуса в меланому
Спровоцировать озлокачествление новообразования могут:
- Травмы (ушибы, порезы и пр.).
- Некачественное и неполное удаление невуса.
- Воздействие ультрафиолетового или радиоактивного излучения.
Диагностика

В комплекс диагностических мероприятий входят:
- Осмотр дерматолога/онколога.
- Дерматоскопия – микроскопическое исследование.
- УЗИ новообразования – для оценки глубины прорастания невуса в слои кожи.
Справка! Биопсия «живой» родинки не осуществляется, так как вследствие этой процедуры невус травмируется, а механическое повреждение способно спровоцировать перерождение в меланому. Поэтому гистологическое исследование проводят после удаления новообразования.
Лечение
Лечение невусов в основном хирургическое. Удалить новообразование можно с помощью:
- Обычного хирургического вмешательства.
- Лазера.
- Электрокоагуляции.
- Радионожа.
- Криодеструкции.
Метод устранения потенциально опасного невуса выбирается врачом в зависимости от характера новообразования, его величины, расположения, состояния организма пациента.
Дерматоскопия родинок
Дерматоскопия кожи , являясь относительно несложным методом прямого визуального изучения состояния кожи, широко используется в онкологической практике. Метод дает ценную информацию о характеристиках кожных образований, прежде всего – родинок. Дерматоскопия родинок очень важна в раннем выявлении признаков их перерождения. Диагностическая дерматоскопия входит в диагностические алгоритмы при различный патологических изменениях кожи, но ее роль в выявлении меланомы трудно переоценить.

Различные модификации методики , в том числе предполагающие получение цифрового изображения (цифровая дерматоскопия), тем не менее, не является самостоятельным методом верификации диагноза меланомы кожи.
Несмотря на невысокую стоимость дерматоскопии в Москве, возможность сделать дерматоскопию в условиях многих медицинских клиник и центров, ее результаты являются лишь дополнением к клиническим данным, и адекватно интерпретируются лишь тогда, когда процедура является частью комплексного диагностического поиска , осуществляемого опытными специалистами – дерматоонкологами.
В связи с этим данный краткий обзор представляет Вашему вниманию не просто описание метода и методологии, а взгляд онколога на результаты дерматоскопии в раннем выявлении меланомы кожи .
Значимыми факторами риска в развитии меланомы кожи являются наличие 1-го и 2-го фототипа кожи у лиц, периодически или регулярно подвергающихся повышенной солнечной инсоляции в результате временного или постоянного проживания в регионах с жарким климатом.
Другими факторами риска являются три и более эпизода солнечных ожогов в течение жизни, присутствие на поверхности кожи веснушек и лентиго, наличие трех и более атипичных меланоцитарных невусов на поверхности кожи.
Весьма важным обстоятельством является то, что у части больных меланома развивается на месте существующего пигментного невуса. Вопреки распространенному мнению, меланомоопасные невусы представляют собой, в основном, приобретенные меланоцитарные невусы, а не врожденные.
Все пигментные невусы на коже человека можно распределить на три клинико-гистологических типа: внутридермальные, пограничные и смешанные (сложные).
Внутридермальные невусы характеризуются своим глубоким залеганием в толще дермы. При этом они приподнимают эпидермис и клинически выглядят в виде горошины или узелка чаще всего светло-коричневых оттенков. Внутридермальные невусы могут быть действительно врожденными или появляются на теле в раннем детском возрасте.
Когда в процессе формирования внутридермального невуса его клетки достигают базальной мембраны, которая отделяет собственно дерму от эпидермиса, возникает смешанный или сложный невус. Клинически он имеет сходство с внутридермальным невусом.

Только иногда вокруг основания подобного узелкового образования может наблюдаться небольшая кайма пигментации, представляющая собой приграничный к дерме и эпидермису компонент. Смешанный невус как и внутридермальный может быть врожденным или сформироваться сразу после рождения.
По большому счету, ни внутридермальный, ни смешанный типы невусов не являются меланомоопасными, хотя часто привлекают к себе внимание из-за не совсем эстетической формы (иногда наблюдается рост редких волосков на их приподнятой поверхности). Но всегда эти «родинки» имеют один доминирующий оттенок цвета от светло- до темно-коричневого, что в последнем случае также ложно настораживает внимание. В действительности должна настораживать не интенсивность пигментации, а наличие полихромии, т.е. разных оттенков.
Онкологическую настороженность следует проявлять в отношении пограничного невуса , который действительно является меланомоопасным. Подобный тип невуса формируется вдоль границы дермы и эпидермиса. Клинически он представляет собой совершенно плоское пигментное образование. Пограничные невусы почти всегда бывают приобретенными. Чаще всего они начинают проявляться на разных участках тела в возрасте 15 – 25 лет. Долгое время их размеры не превышают 2-3 мм. Это создает иллюзию у их носителя, что они существуют с рождения, хотя это не так.

Большинство пограничных невусов так и остаются без изменений годами, однако некоторые из них могут иметь тенденцию к росту. Обычно это длительный процесс. Так за год подобного рода образование может увеличиться всего лишь на 1 мм и таким образом достигнуть размеров до 1 см за несколько лет. Следует помнить, что если плоская приобретенная «родинка» увеличивается и достигает размера 5-6 мм ее следует обязательно показать специалисту. В случае роста пограничного невуса из него может сформироваться диспластический невус – реальный предшественник меланомы кожи. Диспластический невус характеризуется появлением легкой или выраженной ассиметрии, точечных участков депигментации, размерами более 5 мм и склонностью к заметному росту за последние 1-2 года. Нередко эту заметную склонность к росту можно связать с интенсивным воздействием солнечного ультрафиолета (вплоть до ожогов кожи).
Данный процесс может иметь системный характер, в этом случае речь идет о так называемом синдроме множественных диспластических невусов, ассоциированном с меланомой - FAMMM (Familial atypical multiple mole melanoma syndrome). Этот синдром является наиболее значимым известным фактором риска развития меланомы кожи, основным его клиническим проявлением является наличие множества диспластических невусов на поверхности кожи.

Резюмируя вышесказанное, к меланомоопасным образованиям кожи, требующим вторичных профилактических мероприятий можно отнести следующие состояния :
1. Наличие спорадических диспластических невусов у пациента (взрослые/дети).
2. Наличие множественных диспластических невусов у пациента в составе синдрома множественных диспластических невусов, а та кже семейного синдрома множественных диспластических невусов, ассоциированного с меланомой (FAMM) (взрослые/ дети).
Помимо описанных, встречаются редкие пигментные образования кожи, также являющиеся меланомоопасными , к ним относятся:
1. Наличие врожденного гиганского пигментного невуса у детей (дети/взрослые)
2. Наличия веретеноклеточного невуса (синонимы: эпитиелиодный невус, Спиц-невус, ювенильная меланома) (дети/взрослые)
3. Наличие невуса Ота ( глазокожный меланоз) (взрослые/дети)
4. Наличие голубого невуса (взрослые/дети)
5. Наличие гало-невуса (взрослые/дети).
Данные образования кожи не являются онкологическими заболеваниями, они лишь могут являться фоном для их возникновения. В связи с этим, целесообразно наблюдение пациентов с такими состояниями у онколога на договорной основе, обусловленной желанием пациента предупредить развитие заболевания.
Обследования пациентов с перечисленными факторами риска включает в себя на первом этапе общий осмотр , проводимый с целью оценки наличия пигментных образований, а на втором – выполнение эпилюминисцентной дерматоскопии , позволяющей с высокой степенью вероятности выявить меланому кожи на ранней стадии.
Диагностика меланомы кожи первоначально основывается на визуальных признаках проявлений этой опухоли. Диагностический алгоритм первичной оценки пигментного образования включает в себя оценку размера, симметрии, краев, цвета и эволюционных изменений образования, традиционно данный алгоритм описывается правилом ABCDE :
A – asymmetry : оценивается симметричность образования, для меланомы кожи характерна асимметрия, выражающаяся в геометрическом несоответствии одной половины образования другой.
B – boundary : край меланомы кожи обычно неровный, изъеденныый, контуры неровные.
С – color : для меланомы кожи характерна неоднородность окраски, вариабельность цветовой гаммы от черного до белого и голубого.
D – dimension : для меланомы кожи характерен диаметр более 6 мм, однако, данная характеристика не является обязательной.
E – evolution или elevation : какие-либо изменения пигментного образования в течение последних 6 месяцев – года, или образование, возвышающееся над поверхностью кожи (характеризует узловой компонент).

Несмотря на кажущуюся простоту представленного диагностического алгоритма, первоначальная оценка пигментного образования может быть затруднительной. Это связано с широким распространением среди белого населения других образований кожи, внешние характеристики которых могут напоминать меланому кожи: различных меланоцитарных, сложных и пограничных невусов, возрастного лентиго и других. Также следует заметить, что сложности в визуальной оценке образования возникают именно на ранних стадиях меланомы, в фазе горизонтального роста, когда узлового компонента еще нет. Особую сложность в диагностике представляют пациенты с синдромом множественных диспластических невусов, у которых формально могут быть подозрительными на меланому кожи все невусы, количество которых иногда превышает сотню. В этих условиях проведение эксцизионной биопсии практически не представляется возможным и, в связи с этим, требуется более точная предварительная диагностика с учетом того факта, что данный синдром является наиболее значимым фактором риска развития меланомы кожи.
Наиболее значимым и распространенным дополнительным методом диагностики пигментных образований кожи является эпилюминисцентная дерматоскопия , позволяющая оценить, как «классические» ABCD-симптомы при 10-60-кратном увеличении, так и оценить наличие в пигментном образовании специфических дерматоскопических симптомов, характерных для тех или иных образований кожи.
В свете этого в дерматоскопической диагностике меланомы кожи принято два основных алгоритма, учитывающих эти симтомы: это алгоритм Штольца, оценивающий образование по ABCD-системе, и алгоритм Аргезиано, суммирующий баллы, полученные при оценке дерматоскопических характеристик.
В алгоритме Штольца асимметрия образования оценивается в 1 или два балла, в зависимости от того, ассиметричны ли лишь две половины образования или его четверти. Для этого через образование проводится воображаемая линия: если правая половина образования не соответствует левой, то асимметрия оценивается в 1 балл. После этого проводится вторая воображаемая линия, перпендикулярная первой, если и эти две половины не симметричны друг другу, то асимметрия оценивается в 2 балла.
Цвет оценивается по 6-ти балльной шкале, каждый из возможных цветов дает 1 балл в оценке: черный, серо-голубой, светло-коричневый, темно-коричневый, красный, белый.
D в алгоритме Штольца – дерматоскопические структуры, наличие каждой из которых соответствует 1 баллу: точки, глобулы, пигментная сеть, полосы, бесструктурные зоны, т.о., возможно количество баллов по данной характеристике – от 0 до 5.
После подсчета баллов, производится расчет по формуле Штольца - (A x 1,3) + (B x 0,1) + (C x 0,5) + (D x 0,5) = X
При X, равном менее 4,76, вероятность того, что исследуемое образование является меланомой, считается низкой; при X = 4,76 – 5,45 образование считается подозрительным на меланому кожи; при Х более 5,45 образование считается меланомой кожи до подтверждения или опровержения по результатам морфологического исследования.
В алгоритме Аргезиано оценивается наличие дерматоскопических структур, характерных для меланомы кожи. При этом, часть структур, наиболее часто встречающихся именно в меланоме оцениваются в 2 балла (major criteria), а другая часть, часто встречающаяся в других пигментных образованиях – в 1 балл (minor criteria).
К главным структурам относятся: атипичная пигментная сеть, бело-голубая вуаль и атипичные сосудистые структуры: точечные или линейный сосуды, видимые при исследовании.
К второстепенным критериям относятся нерегулярная окраска образования, наличие в образование точек и глобул, регрессивных структур.
При оценке образования по Аргезиано суммируются баллы, и в том случае, если сумма более или равно 3, образование считается подозрительным на меланому кожи.

Таким образом, при использовании эпилюминисцентной дерматоскопии в большинстве случаев удается дифференцировать меланому кожи от доброкачественных образований , выделить образования, требующие эксцизионной биопсии, и образования, требующие динамического наблюдения. В случаях с пациентами с FAMMM-синдромом, динамический контроль с помощью данного метода исследования является адекватным способом вовремя оценить изменения в диспластическом невусе и профилактически иссечь его, либо диагностировать развивающуюся на фоне диспластического невуса меланому на ранней стадии.
В нашей клинике мы предлагаем консультацию одного из лучших онкодерматологов кандидата медицинских наук Игоря Евгеньевича Синельникова, включающую дерматоскопию с изучением состояния родинок, а при необходимости – высокоразрешающее ультразвуковое сканирование кожи.
Помимо этого, наши возможности позволяют осуществить любые виды ультразвукового исследования внутренних органов и лимфатических узлов, а в условии агентской клиники – мультиспиральную компьютерную томографию и магнитнорезонансную томографию на оборудовании лучших мировых производителей. Мы также предлагаем и многие другие услуги.
Следует помнить: только ранняя диагностика меланомы кожи позволяет успешно лечить это грозное заболевание.
Невус
Невус (пигментное пятно, пигментный невус, меланоцитарный невус) – доброкачественное новообразование, которое в большинстве случаев является врожденным пороком развития кожи.
На ограниченном участке образуется скопление особых клеток – невоцитов, которые содержат большое количество пигмента меланина.
Невоциты являются патологически измененными меланоцитами – клетками, которые в норме синтезируют меланин и придают окраску коже. Невоклеточный невус – синоним пигментного невуса. Родинка и невус – также идентичные понятия (сам термин происходит от латинского слова naevus – "родинка").
Лечением и профилактикой невусов занимается врач-дерматолог.
Виды невусов:

Меланоцитарные невусы отличаются большим разнообразием форм, цветов и размеров. До настоящего времени среди врачей нет однозначного мнения по поводу того, какие образования следует обозначать словом "невус".
Поэтому иногда невусами называют доброкачественные кожные опухоли, в которых не содержится пигмент меланин: Гемангиомы – сосудистые опухоли.
Особенно распространено понятие "клубничный невус" - гемангиома красного цвета, которая имеется у большинства новорожденных детей, и проходит в течение первого года жизни.
Также многие врачи оперируют таким понятием, как сосудистый невус.
Невусы сальных желез – в большинстве случаев расположены на голове, также не содержат меланина. Такое новообразование известно как сальный невус.
Иногда врожденными невусами у детей также называют тератомы (гамартомы), которые, по сути, являются врожденными опухолями, состоящими не только из кожи, но и из всех остальных тканей.
Анемичный невус – разновидность сосудистого невуса. Это участок кожи, на котором недоразвиты сосуды, поэтому он имеет более светлую окраску.
Настоящий меланоформный невус – это образование, которое происходит из измененных клеток-меланоцитов – невоцитов.
Различают следующие виды невусов:
Невоклеточный пограничный невус – простое пятно, которое не возвышается на коже, или слегка выступает над ее поверхностью. Пограничный невус имеет четкие контуры и коричневую окраску. Он может иметь различные размеры и располагаться на разных частях тела. При данном виде меланоформного невуса скопление клеток с пигментом находится между верхним (эпидермис) и средним (дерма) слоем коже – такое расположение обозначается как внутриэпидермальный невус.
Интрадермальный невус – наиболее распространенная разновидность меланоформного невуса. Он так называется, потому что скопление пигментных клеток находится в толще среднего слоя кожи – дерме.
Пигментный сложный невус кожи. Такой невус имеет вид родинки: он возвышается на кожей и может иметь различную окраску, от светло-коричневой до практически черной. Часто на нем растут жесткие волосы. Смешанный невус имеет гладкую поверхность, и может находиться на любой части тела.

Внутридермальный невус. Также выступает над поверхностью кожи, но, в отличие от сложного невуса, имеет неровную, бугристую поверхность. Практически всегда расположен на голове или на шее, очень редко – на туловище. В большинстве случаев внутриэпидермальный невус появляется в возрасте 10 – 30 лет.
Со временем он как бы отделяется от кожи, и располагается на тонкой ножке. Часто затем он превращается в папилломатозный невус (бородавчатый невус). В нем образуется большое количество неровностей, складок и щелей, в которых скапливаются отмершие клетки верхнего слоя. Здесь могут скапливаться болезнетворные организмы, которые затем приводят к инфекционным процессам.
Голубой невус имеет характерную окраску, так как он связан с отложениями меланина под кожей. Голубые невусы характерны в основном для азиатских национальностей. Они немного возвышаются над кожей, плотные на ощупь, их поверхность всегда гладкая, на ней никогда не растут волосы. Голубой невус имеет небольшую величину, чаще всего не более пяти миллиметров.
Базальный невус также имеет вид родинки, но чаще всего он обладает обычным телесным цветом. Это – беспигментный невус.
Невус сетона (невус сеттона, невус саттона, гало невус) – особая разновидность дермального невуса, когда вокруг пигментного пятна находится участок кожи, полностью лишенный пигмента. Происхождение таких невусов пока до конца не изучено. Они часто сочетаются с витилиго (потерей кожей пигментов), меланомами. Чаще всего в области гало невуса имеется небольшое воспаление в коже.
Невус Ота. Располагается на лице, с одной стороны, в виде "грязных" пятен.
Невус Ита напоминает невус Ота, но он находится под ключицей, на груди, в области лопатки и шеи. Обе этих разновидности встречаются в основном у представителей азиатских народов.
Папилломатозный невус (бородавчатый невус). Похожий на папиллому невус часто имеет большие размеры, находится на голове или сзади на шее, но может располагаться и в иных местах. Он имеет неровную поверхность, как бородавка. Часто на нем растут волосы.
Невус Беккера (волосяной эпидермальный невус) – чаще сего возникает у мальчиков и юношей 10 – 15 лет. Сначала на теле образуется несколько мелких пятен, которые имеют светло-коричневую или коричневую окраску, и находятся рядом. Затем они сливаются и образуют пятна с неровными контурами размерами до 20 см. После этого пятна приобретают неровную бородавчатую поверхность, покрываются волосами. Считается, что к росту невусов Беккера приводит выброс в кровь большого количества мужских половых гормонов – андрогенов.

Линейный невус – новообразование, которое появляется с рождения. Представляет собой множество мелких узелков, от светлого до практически черного цвета, которые расположены на коже в виде цепочки. Линейный невус может занимать всего пару сантиметров, а может и всю руку или ногу. Иногда на нем растут волосы.
Невус глаза – пигментный невус, который расположен на радужной оболочке. Он хорошо заметен в виде пятна, которое может иметь разные размеры и форму. Также невус глаза может находиться на сетчатке: в этом случае он выявляется только во время осмотра офтальмологом.
- мелкие невусы, имеющие размеры 0,5 - 1,5 см;
- средние неводермальные невусы - 1,5 - 10 см;
- крупные пигментные невусы имеют размеры более 10 см;
- если невус располагается на целой области тела, занимая ее практически целиком, то он называется гигантским.
Со временем внешний вид пигментных невусов может изменяться. Меняется и их общее количество на теле: Далеко не всегда можно обнаружить невусы на теле новорожденного. Только у 4 – 10% детей грудного возраста можно выявить родинки. Если невусы с рождения имеют большие размеры, то они наиболее опасны в плане озлокачествления (перехода в меланому).
В подростковом возрасте (10–15 лет) дермальные невусы можно встретить у 90% лиц.
В среднем у человека в возрасте 20-25 лет на теле можно насчитать до 40 родинок.
После 30 лет на коже остается только 15 – 20 невусов.
У человека, достигшего 80 – 85 лет практически невозможно обнаружить невусы на теле. Такую динамику связывают с изменением гормонального фона в течение жизни человека.
Причины возникновения:
Многие исследователи склоняются к мысли, что абсолютно все пигментные невусы, даже те, которые появляются с возрастом, являются врожденными пороками развития кожи.
Нарушения, которые приводят к образованию этой доброкачественной опухоли, возникают еще в эмбриональном состоянии организма. До настоящего времени пока не изучены все врожденные причины образования диспластических невусов.
В качестве основных факторов можно выделить:
Колебания уровня половых гормонов в организме беременной женщины:
- прогестинов и эстрогенов.
- Инфекции мочеполовой системы у беременных. Воздействие на организм беременной женщины неблагоприятных факторов: токсичных веществ, излучений.
- Генетические нарушения. Под действием всех этих факторов нарушается развитие меланобластов – клеток, из которых впоследствии образуются меланоциты. В итоге меланобласты скапливаются на определенных участках кожи и трансформируются в клетки-невоциты.
Невоциты отличаются от нормальных меланоцитов двумя особенностями:
- У них нет отростков, по которым пигмент мог бы распространяться в другие клетки кожи;
- Диспластические невусы хуже подчиняются общим регулирующим системам организма, но, в отличие от раковых клеток, утратили эту способность не полностью.
- Гормональные перестройки организма. Это очень ярко проявляется в подростковом возрасте, когда на теле появляется большая часть невусов.
- Действие на кожу ультрафиолетовых лучей. Частые солнечные ванны и солярии способствуют росту пигментных пятен.
- Беременность. Как уже отмечалось выше, это связано с колебанием уровня половых гормонов в организме женщины.
- Менопауза.
- Прием контрацептивов.
- Воспалительные и аллергические заболевания кожи (угри, дерматиты, различные сыпи).
Диагностика невусов:
Перед врачом, который осуществляет диагностику невуса, стоит ряд важных задач:
- установить разновидность невуса и определить возможности его лечения;
- вовремя распознать начало процесса озлокачествления пигментного пятна;
- определить показания к проведению дополнительных методов диагностики.
Обследование пациента начинается классически с беседы и осмотра. Во время расспроса врач устанавливает важные подробности: когда появился неводермальный невус.
Особенно важно, имеется ли он с рождения, или возник с возрастом; как образование вело себя в течение последнего времени:
- увеличивалось ли в размерах,
- изменяло ли цвет, контуры, общий внешний вид;
- проводилась ли ранее диагностика и лечение, каков был результат

Непосредственный контакт с пациентом очень важен. Ни один профессиональный специалист не возьмется ставить диагноз и лечить невус по фото. После расспроса пациента следует осмотр. Доктор должен оценить форму, размер, расположение невуса, наличие на нем волос и иные особенности. После этого уже может быть поставлен точный диагноз и намечены определенные лечебные мероприятия.
При необходимости врачом назначаются дополнительные методы диагностики. Чаще всего применяются мазки с поверхности невуса. Абсолютными показаниями к данному исследованию является мокнутие, кровоточивость, трещины на поверхности пигментного пятна. Во время мазка получают материал, который затем изучают при помощи микроскопа.
Лабораторная диагностика применяется для установления процесса перерождения невуса в меланому. При озлокачествлении пигментного пятна в крови пациента появляются особые вещества – онкомаркеры. Их обнаружение позволяет точно установить диагноз, так как только при меланоме в крови определяются две молекулы, имеющие название TA90 и SU100. При других злокачественных опухолях выявляются другие онкомаркеры.
Для проведения анализа на онкомаркеры необходимы четкие показания: врач должен иметь веские основания подозревать переход невуса в меланому. Кроме того, само удаление дермального невуса может стать диагностической процедурой.
После того, как пигментное пятно удалено, врач отправляет его на гистологическое исследование. Маткриал осматривают под микроскопом и, в случае обнаружения злокачественного перерождения, пациента снова просят явиться в клинику.
Лечение невуса:
В настоящее время существует несколько методов лечения пигментных невусов, как хирургическим путем, так и альтернативными способами.
Показания определяются только лечащим врачом с учетом двух факторов:
Особенности самого пигментного пятна: разновидность, размеры, риск перехода в меланому.
Наличие в больнице необходимого оборудования
Хирургический метод
Удаление пигментного невуса хирургическим путем (при помощи скальпеля) – наиболее распространенная методика, так как она не требует специального оборудования и отличается надежностью.
Криодеструкция
Криодеструкция – метод, предусматривающий лечение невуса при помощи заморозки. После обработки низкими температурами пигментное пятно отмирает и превращается в струп (корочку), под которой растет новая нормальная кожа.Лечение невуса низкой температурой может осуществляться только в том случае, если он имеет небольшие размеры, и расположен поверхностно, но не сильно выступая над кожей.
Электрокоагуляция
Это методика, которая противоположна криокоагуляции. Иссечение невуса осуществляется под действием высокой температуры.Процедура болезненная, поэтому требует применения местной анестезии, а у детей – только общего наркоза.
Лазерная терапия
Удаление невусов лазером – метод лечения, который широко распространен в современных косметологических салонах. Он отлично подходит для того, чтобы удалять небольшие родинки в области лица, шеи и на других частях тела. Лазерное излучение отличается тем, что оно способно проникать в кожу на большую глубину в пределах точно заданной площади. При этом не образуется шрамов, ожогов, рубцов и других осложнений. Процедура безболезненна.
Радиохирургические методы
В последние годы радиохирургия все активнее используется в мировой медицине. Суть этих методик состоит в том, что специальным прибором, - радионожом (сургитроном) генерируется пучок радиоактивного излучения, который концентрируется только в области патологического очага, не нанося вреда здоровым окружающим тканям. Таким образом могут быть удалены практически любые доброкачественные и злокачественные опухоли, в том числе и пигментные невусы.
Некоторые особые показания Если имеется подозрение на злокачественное перерождение невуса, то используется, как правило, только хирургическое иссечение.
При этом удаляются все окружающие ткани, для предотвращения дальнейшего роста опухоли. Некоторые разновидности невусов лечатся только хирургическим путем.
Большинство методов лечения невусов проводится в нашей клинике опытными врачами-дерматологами. Для получения консультации и записи на прием, звоните или записывайтесь через форму.
Читайте также:
